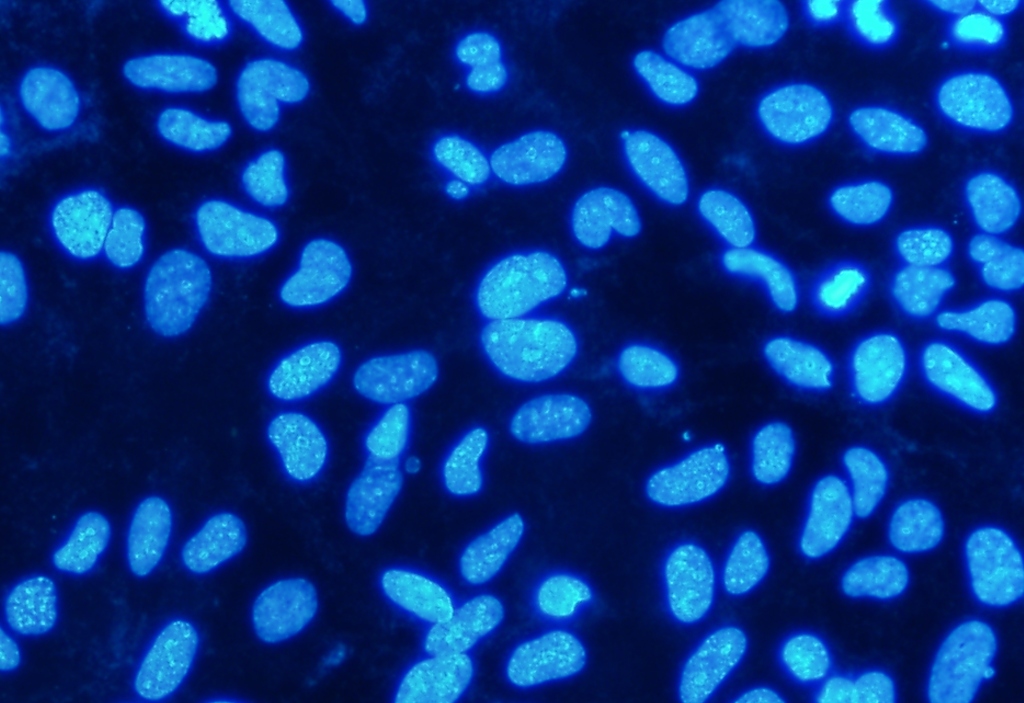
Consistent results

Univisual uses advanced AI to automatically analyze complex microscopic images with speed and accuracy, delivering the insights you need in seconds—not hours.

By signing up you agree to our Terms and Conditions.
See measurable improvements across your operations

AI-powered detection, segmentation, and counting with scientific precision.

Web-based. No installation. No extensive study time. Automate repetitive visual tasks and focus on strategy.
Learn
Support for large, multi-gigapixel images. Consistent, reproducible analysis across experiments. Expert-in-the-loop correction and validation.

Hear from teams using Univisual
“We cut our quality control time in half and caught defects we'd been missing for months.”
“The speed alone changed how we work, but the accuracy is what made us believers.”
“Our team went from drowning in images to making decisions in minutes.”
Everything you need to know about Univisual